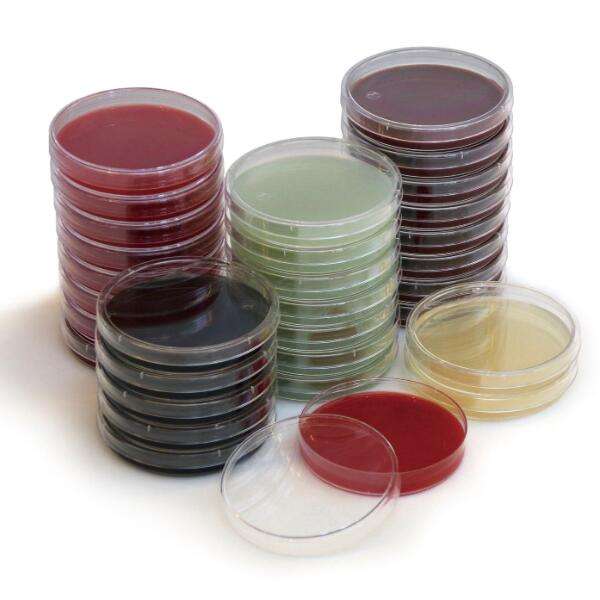
平板计数琼脂平板(pcr)

平板计数琼脂

海博平板计数琼脂pcahb0101250g瓶
图片尺寸591x685
022070p1平板计数琼脂pca培养基颗粒250g
图片尺寸3347x3347
平板计数琼脂培养基培养皿pca10个90mm无菌平皿平板板子可oem 10皿/包
图片尺寸990x990
平板计数琼脂pca br250g/瓶
图片尺寸1920x1920
平板计数琼脂pca培养基瓶装颗粒
图片尺寸790x700
平板计数琼脂平板(pcr)
图片尺寸600x600
平板计数琼脂 (pca)cm101 250g 北京陆桥 大量现货!-阿里巴巴
图片尺寸270x360
平板计数琼脂培养基pca100g-250g卫生微生物检验实验用品 100g
图片尺寸1000x1000
麦康凯琼脂平板(9cm) hbpm016 10个/包 青岛海博生物
图片尺寸400x400
博微 平板计数琼脂培养基pca化学实验用品 微生物检验250g干粉
图片尺寸480x480
北京陆桥|平板计数琼脂|微生物培养基|培
图片尺寸1080x1920
正品平板计数琼脂pca培养基实验卫生微生物检验生化试剂细菌总数
图片尺寸1000x1000
平板计数琼脂培养出来的东西,帮我看看这个是什么情况?
图片尺寸1280x1280
022070p1平板计数琼脂pca培养基颗粒250g
图片尺寸3347x3347
豫安宁 平板计数琼脂(sn) 培养基 250克 化学试剂 实验用品
图片尺寸310x310
平板计数琼脂培养基pca细胞总数计数90mm
图片尺寸1920x1920
平板计数琼脂pca海博陆桥干粉培养基
图片尺寸960x960
海博平板计数琼脂r2a琼脂na培养基牛肉膏蛋白胨营养肉汤培养基 平板
图片尺寸800x800
平板计数琼脂(pca) 袋装即用型
图片尺寸1000x1000
平板计数琼脂培养基(pca)250g 上海 食品卫生微生物检验
图片尺寸800x800